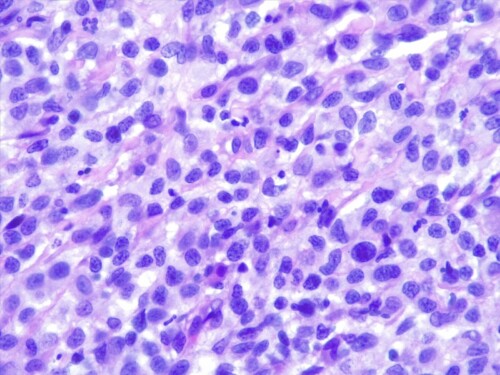

Une chatte stérilisée Européenne de 12 ans, à pelage blanc uniforme, est présentée en avril 2023 pour la persistance et l’aggravation récente de plaques croûteuses sur la face, indolores et non prurigineuses.
Elle a accès à l’extérieur une partie de l’année dans le Sud de la France en fonction des déplacements de sa propriétaire. Elle est correctement vaccinée, régulièrement traitée contre les ectoparasites (lotilaner Credelio®), les endoparasites (milbémycine associé au praziquantel MILBEMAX®), et n’a présenté aucun souci de santé notable jusqu’à présent.
Jean-Loup MATHET
Septembre 2024
Commémoratifs
Les premières lésions, alopéciques et discrètement érosives, sont apparues en décembre 2022, l’une sur la joue de 8mm et l’autre palpébrale de 6mm. Une culture mycologique réalisée alors par la méthode du carré de moquette est stérile (laboratoire DPM Oniris). L’application d’une pommade d’acide fusidique (Forudine®) semble stabiliser la situation : une amélioration est même rapportée par la propriétaire jusqu’en mars 2023 puis les lésions s’aggravent à nouveau.
Un examen histopathologique est proposé mais malgré tout refusé la propriétaire qui est plutôt non interventionniste.
Examen clinique
La chatte revient en consultation en juin 2023 pour poursuite de la dégradation clinique. On observe une extension lésionnelle et l’apparition de nouvelles plaques croûteuses et squameuses indurées, indolores, parfois ulcératives, toujours sur la tête (photos 1 et 2). Une hypertrophie du ganglion rétro-mandibulaire droit est maintenant palpable.
Le bilan clinique est donc une dermatose alopécique, érythémateuse et croûteuse, non prurigineuse, d’évolution chronique, de localisation exclusivement faciale (joue, chanfrein, paupières), caractérisée par des plaques et des nodules, associée à une adénomégalie unilatérale rétro-mandibulaire.
Hypothèses diagnostiques
Il faut considérer principalement une mycose superficielle (dermatophytie, dermatite à Malassezia) voire profonde (cryptococcose, sporotrichose), une pyodermite associée à un prurit cervico-facial dont l’étiologie sous-jacente reste à déterminer, une dermatose virale (moins probable en l’absence de signes cliniques généraux), et enfin une tumeur de croissance lente (lymphome, mastocytome, carcinome épidermoïde, sarcome des tissus mous).
Le trichogramme est normal, quelques bactéries sont observées sur les cytologies par calque par apposition. Par précaution, une nouvelle moquette pour recherche de dermatophytes est demandée, et revient encore négative.
Des biopsies cutanées sont finalement acceptées et envoyées au laboratoire LAPVSO (Toulouse) en zones centrale et périphérique lésionnelles. Dans l’attente, une antibiothérapie probabiliste (association amoxicilline et acide clavulanique Kesium®) et une injection de déxaméthasone (Dexafort®) sont administrées, associées à une antisepsie par lingettes (Douxo Pyo Pads®).
Les résultats d’histopathologie confirment une lésion proliférative tumorale plus qu’inflammatoire, évocatrice d’une histiocytose progressive féline à cellules dendritiques.
Le derme est envahi par une plage cellulaire dense diffus, peuplé majoritairement de cellules rondes indépendantes présentant une allure histiocytaire, des granulocytes neutrophiles et quelques cellules lymphoplasmocytaires.. Elles sont dotées d’un noyau discrètement plicaturé à chromatine à tendance hyperchromatique finement mottée autour de plusieurs nucléoles. Le cytoplasme est abondant acidophile et présente des limites imprécises. On observe également une anisocaryose, et parfois des cellules plurinucléées, et une forte activité mitotique. Les annexes cutanées sont atrophiées et emprisonnées au sein de cet infiltrat. Aucun élément figuré pathogène parasitaires ou fongiques n’est visible sur la réaction au PAS ni sur les différents de section effectués. L’épiderme est ulcéré et hyperplasique.
Le diagnostic définitif est donc une histiocytose dendritique progressive féline.
Traitement
Une corticothérapie orale est alors initiée courant juin (prednisolone Dermipred®, à la dose de 1mg/kg/jour les premiers jours puis 0,5 mg/kg/j, associée à des soins locaux des lésions palpébrales (pommade ophtalmologique framycétine et déxaméthasone Fradexam®) et à une éviction solaire. L’amélioration clinique est rapidement constatée avec réduction modérée de la taille des lésions et – sans surprise – de leur aspect inflammatoire (photo 3). Le ganglion rétro-mandibulaire a également diminué de taille.
La propriétaire rapporte également une meilleure qualité de vie de la chatte, mais ne souhaite pas de prise en charge spécialisée en chirurgie cancérologique ni radiothérapie. La corticothérapie est donc poursuivie ensuite en cures régulières en fonction de l’évolution lésionnelle. La taille est l’extension loco-régionale des plaques et les nodules sont fluctuantes durant plusieurs mois. Les corticoïdes sont arrêtés en fin d’année.
Une rechute plus sévère est observée début février 2024 (photos 4 et 5) et conduit à une reprise de la corticothérapie d’abord injectable (dexaméthasone) puis orale (prednisolone). La réponse clinique est cette fois-ci plus discrète, avec stagnation lésionnelle pendant quelques semaines puis aggravation fin mars (photo 6).
La propriétaire demande l’euthanasie de son animal en avril dernier face à la dégradation clinique (photo 7).
Discussion
Les dermatoses histiocytaires nodulaires regroupent chez le chien et moins fréquemment chez le chat un ensemble d’entités réactionnelles ou tumorales, d’évolution variable, liées à la prolifération de cellules leucocytaires spécifiques : les histiocytes.
Les histiocytes regroupent trois sous-populations dérivant d’un précurseur commun CD 34+ : les monocytes (circulants sanguins), les macrophages (tissulaires) et les cellules dendritiques myéloïdes regroupant les cellules de Langherans localisées dans l’épiderme et les cellules dendritiques sensus stricto interstitielles et dermiques.
Les histiocytoses réactionnelles peuvent être associées à des pathologies infectieuses (leishmaniose), des dépôts intradermiques amorphes (amyloïdose ou xanthomatose), ou à des corps étrangers.
On distingue aussi une forme cutanée, avec possible guérison spontanée et une forme systémique d’histiocytose réactionnelle à infiltrat inflammatoire strict. Ce sont des maladies inflammatoires complexes liées à une dérégulation immunitaire sous-jacente
Les tumeurs histiocytaires regroupent l’histiocytome cutané canin parfois auto-involutif, les histiocytoses félines, et les sarcomes histiocytaires localisés ou disséminés (histiocytose maligne).
Les troubles histiocytaires félins incluent l’histiocytose progressive, l’histiocytose pulmonaires à cellules de Langherans et le sarcome histiocytaire localisé ou disséminé. On n’observe pas de maladies cutanées liées aux cellules de Langherans chez le chat.
L’histiocytose progressive féline, plutôt peu décrite au départ, est maintenant plus fréquemment diagnostiquée. Elle se manifeste par une ou des lésions cutanées nodulaires, indolores et non prurigineuses initialement, alopéciques et parfois ulcératives, d’évolution lente, souvent fluctuantes. Les doigts et les extrémités des membres, la tête et le tronc sont les zones plus atteintes. Les complications métastatiques viscérales (foie, rate, reins, poumons, moelle osseuse, SNC, plèvres) ou ganglionnaires apparaissent tardivement. Les formes très avancées sont indissociables d’un sarcome histiocytaire primaire. Aucune régression spontanée n’a été rapportée.
La maladie concerne des chats d’âge moyen à avancé, entre 9 et 14 ans, et un nombre de femelles atteintes légèrement supérieur aux mâles, sans prédispositions raciales. L’espérance de vie est variable et peu prédictible : de quelques semaines à plusieurs années.
Dans une étude de 2019 (COSTE et al.), le suivi de 26 cas a permis de déterminer un intervalle de survie très étendu (de 41 à 1449 jours) selon les modalités de prise en charge. L’exérèse chirurgicale précoce et large, en marges saines idéalement, est le traitement de choix. La médiane avant récidive post-chirurgie est de 6 mois environ, mais les chats sans récidives présentes une médiane de presque 1000 jours, voire de plus de 4 ans. Les alternatives à la chirurgie sont la radiothérapie locale, les corticoïdes, le masitinib, mais avec des résultats inconstants et de faibles taux de survie.
Le diagnostic différentiel inclus les tumeurs à cellules rondes dont les mastocytomes atypiques, les mélanomes achromiques, les lymphomes, les plasmocytomes mais aussi certaines inflammations et infections granulomateuses (fongiques, mycobactérioses).
L’histopathologie se caractérise par un infiltrat dermique et sous-cutané histiocytaire mal délimité, non-encapsulé. Cet infiltrat se compose de cellules rondes à polygonales à rapport nucléo-cytoplasmique bas, et cytoplasme éosinophilique ou finement granuleux, un noyau ovale ou indenté et chromatine mottée. Un épithéliotropisme – agrégats intra-épidermiques de cellules tumorales – est présent dans une proportion non négligeable , 42% selon la même étude.
Des cellules plurinucléées sont parfois notées, associées à un nombre de mitoses variable. La présence d’atypies cellulaires (pléomorphisme, anisocytose et anisocaryose), d’un index mitotique élevé et de la présence d’emboles intra-lymphatiques ou intravasculaires sont associées à des formes disséminées.
Les marquages immunohistochimiques sont indispensables pour le diagnostic de certitude d’une HPF. Les marqueurs les plus utilisés sont le marqueur histiocytaire MHC II, le marqueur de cellules histiocytaires de Langherans CD18, et l’E-cadherine (glycoprotéine transmembranaire d’adhésion cellulaire) qui semble variablement exprimée. Ces marquages permettent entre autres de différencier une origine dendritique d’une origine de cellules de Langherans. De même, l’index de prolifération cellulaire Ki67 (< ou > à 15%) présente un intérêt pronostique particulier sur l’estimation du taux de survie global.
Conclusion
L’HPF est une forme initialement indolente de sarcome histiocytaire, de bas grade, localisé à la peau, susceptible de métastaser tardivement à divers organes, et d’évolution peu prévisible.
Cette entité rare, cliniquement peu spécifique, au décours fluctuant, et ne répondant pas aux traitements classiques, doit être inclue dans le diagnostic différentiel des dermatoses nodulaires félines. Une prise en charge chirurgicale précoce et complète lorsqu’elle est réalisable est à privilégier.
Sincères remerciements au Dr Frédérique DEGORCE pour les clichés histopathologiques.
Bibliographie
COSTE M et al. Feline progressive histiocytosis: a retrospective investigation of 26 cases and preliminary study of Ki67 as a prognostic marker. J Vet Lab Diagn 2019; 31: 801-8.
COSTE M et al. Feline progressive histiocytosis: a retrospective investigation of 26 cases and preliminary study of Ki67 as a prognostic marker. J Vet Lab Diagn 2019; 31: 801-8.
HIRABAYASHI M. et al. Immunophenotyping of Nonneoplastic and Neoplastic Histiocytes in Cats and Characterization of a Novel Cell Line Derived From Feline Progressive Histiocytosis. Vet Pathol 2020 57(6).
MOORE P.F Histiocytic Diseases. VCNA: Small animal practice. 2023. (51)1.
MOORE P.F. A review of histiocytic diseases of dogs and cats.Vet Pathol 2014 51(1)167-184.
MULLER A. Tumeurs cutanées à cellules rondes chez le chat : l’histiocytose progressive féline p127. Proceedings du GEDAC 2023. ST-MALO.
PINTO DA CUNHA N. Cytologic and immunocytochemical characterization of feline progressive histiocytosis. Vet Clin Pathol 2014 43(3).